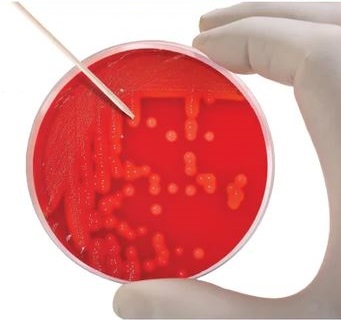
Capture 2

Description
The ‘smart’ way to isolate individual colonies available in three lengths and two needle sizes to suit a wide range of application needs
Features and Benefits:
- Naturally biodegradable, made from 100% U.S.A grown white birch wood
- Manufactured in an fda-registered factory and comply with FDA standards for food contact
- Available in semi or needle point styles for delicate operations
- Autoclavable to 121°C
- Disposable